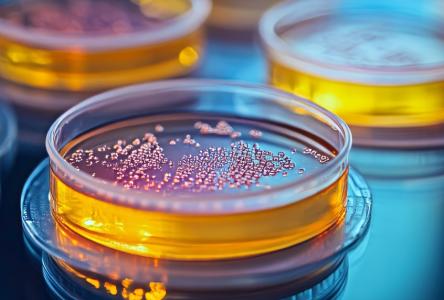
C'est la découverte de microbes intestinaux qui libèrent des acides biliaires anticancéreux permettant de bloquer les signaux hormonaux du cancer (Visuel Adobe Stock 1115430229)

MICROBIOTE INTESTINAL : Ces acides biliaires naturellement anticancéreux
Cette découverte, de microbes intestinaux qui libèrent des acides biliaires anticancéreux permettant de bloquer les signaux hormonaux du cancer, ouvre à l’évidence de nouvelles perspectives prometteuses pour stimuler la réponse immunitaire antitumorale. L’étude, menée par une équipe de biologistes et d’endocrinologues de la Weill Cornell Medicine (New York) et publiée dans la revue Cell, suggère en pratique que l'introduction de microbes intestinaux ciblés chez les patients atteints de cancer avant le traitement, ou l'administration directe d'acides biliaires anticancéreux dans le cadre du traitement pourraient rebooster la réponse immunitaire anticancéreuse.
Pour continuer à lire cette actualité, vous devez être membre Premium.

Je souhaite devenir membre PREMIUM
Accèdez sans limite aux 15 000 actualités du site et recevez gratuitement chaque semaine, la Newsletter Santé log avec les actus Santé à ne pas manquer !

Je suis déjà
membre PREMIUM
Devenez membre PREMIUM
Accèdez sans limite aux 15 000 actualités du site
et recevez gratuitement chaque semaine,
la Newsletter Santé log avec les actus Santé à ne pas manquer !

Je suis déjà membre PREMIUM
Autres actualités sur le même thème
CANCER de la PROSTATE : Un simple test de spermine urinaire pour le détecter
Actualité publiée il y a 5 années 1 moisGLIOBLASTOME : Ettouffer les cellules tumorales
Actualité publiée il y a 2 années 10 moisMÉLANOME et PARKINSON : Le gène de la rousseur, un facteur de risque commun ?
Actualité publiée il y a 9 années 1 moisCANCER COLORECTAL : La durée de l’obésité fait toute l’ampleur du risque
Actualité publiée il y a 3 années 11 mois
ABONNEMENT PREMIUM
Accédez sans limite à plus de 15 000 actualités




